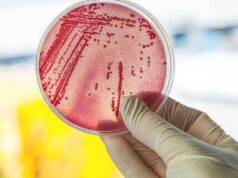
Что такое посев эякулята и для чего он нужен

Что такое посев эякулята и для чего он нужен
Бактериологический посев спермы — это вид лабораторного исследования, в результате которого определяется уровень присутствия патогенной и условно патогенной микрофлоры и...
Как выиграть в букмекерской конторе Париматч?
За несколько лет ставки на спорт онлайн заняли довольно большое место по сравнению со всеми другими классическими ставками. Действительно, достижения...
Акции в онлайн казино Вулкан
Бонусный баланс Вулкан онлайн будет аннулирован, если игрок не выполнит требования по ставкам в течение двух месяцев с момента запроса...
Как организовать поминки?
Организационные вопросы, которые возникают после смерти близких, по праву считаются самыми сложными. Они не только требуют учета множества нюансов, но...
Казино Вулкан 24: окунитесь в мир драйва и веселья
Если предпочитаете бонус казино, вам необходимо внести не менее 10 фунтов евро. Сделайте так, чтобы казино Вулкан 24 официальный сайт...